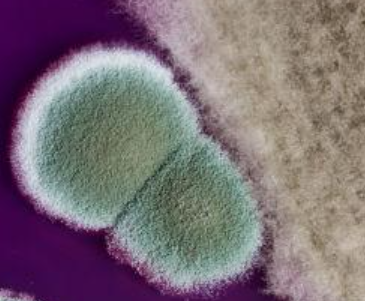
配图2

最近半年来,24岁的小伙子小王(化姓)总是咯血,每次量不多,但反复发作,在当地医院就诊后经抗感染、止血治疗效果不理想。在病友推荐下,他跨市找到杭州市红十字会医院(浙江省中西医结合医院)何飞主任中医师求诊。
小王告诉何飞,这半年以来,他每天下午起咳嗽就会增多,间断痰中带血,曾去当地多家医院就诊检查,抽血化验各项指标炎症指标轻度升高,其他基本正常,有医生怀疑是“肺结核”感染,结果肺部CT检查提示陈旧性肺结核,伴有支气管扩张,并没有新发感染病灶,多次痰找抗酸杆菌均是阴性,最终只开了点常规抗感染、止血、止咳化痰药,效果并不好。
“您之前感染过肺结核吗?目前体重多少?”何飞主任师仔细查看病史及相关检查结果后问道。
“我5年前得过一次肺结核,但当时都已经治好了,后面也没再咳嗽。最近几年体重倒是下降得厉害,我身高170cm,现在都快要不到了90斤了!”
何飞仔细查阅了小王的肺部CT片,除了陈旧性肺结核病支气管扩张病灶外,部分囊状的支扩里面已有了典型的曲霉球病灶,进行多次痰真菌培养后,培养到了曲霉菌,并由此诊断其患上了“慢性肺曲霉病”。

何飞向小王解释,当时肺结核虽然治好了,但它的并发症却被忽视了。肺结核治愈后,因为长期的结核菌感染破坏,胸廓和气道结构会被不同程度破坏,若没有及时干预和长期管理,就容易出现像支气管扩张症、肺曲霉病等病症,医学界称之为结核后肺疾病(PTLD)。诊断明确后,何飞采用了中西医结合综合的治疗方案,一个月后复诊,小王的咯血基本停止了。
何飞说,马上要到“世界防治结核病日”了,据估计,2020年有1.55亿结核病幸存者在世,高达60%的幸存者会出现呼吸功能损害,结核病的影响并不会在治疗完成后结束,结核后肺疾病将对许多治愈患者产生了不利影响。结核后肺疾病是一个被长期忽视的问题,在临床中像小王这样的情况经常会遇到。有些患者结核病已治愈,但之后又会出现新的呼吸道症状,以及肺和支气管结构改变等情况。所以,即使进行了足量、足疗程抗结核治疗后仍可能残留永久性的肺部结构和功能上的损伤,包括支气管扩张症、慢性阻塞性肺疾病、慢性肺曲霉病、气道狭窄、支气管血管畸形和纤维化等,出现各种临床并发症,需要我们警惕。
何飞建议,在肺结核疗程结束后患者还需要到呼吸相关专科进行临床评价与干预。临床评估的内容应包括体重指数,肺结构变化、肺功能变化和症状积分变化等,同时评估是否存在霉菌定植或感染的风险,并提醒患者避免接触潮湿阴暗环境。